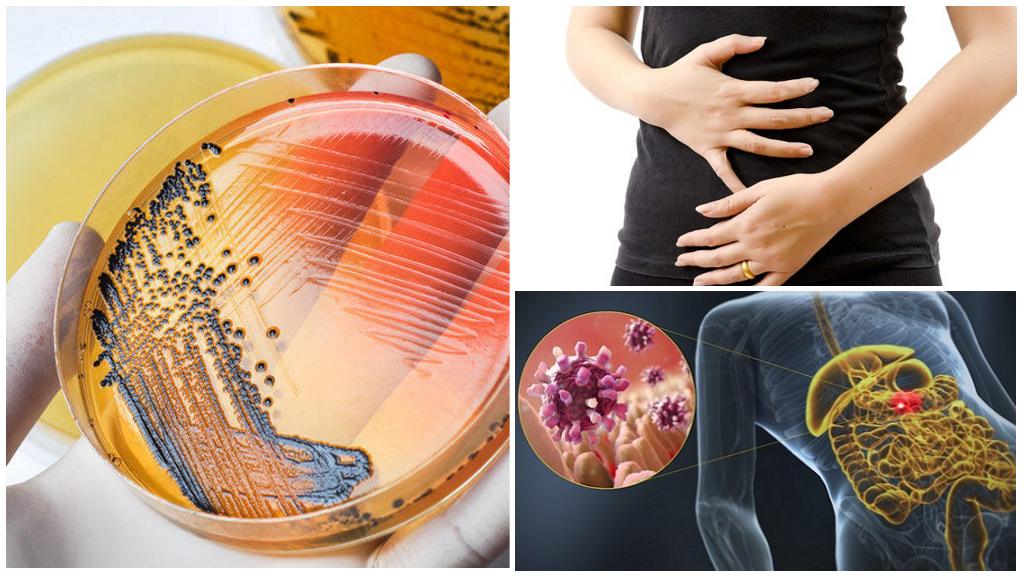

Использование насекомых
Несмотря на то что тараканы — неприятные и опасные для человека насекомые, не все они уничтожаются. Тараканы используются:
- Как участники тараканьих бегов. Речь идет о гигантских тараканах с Мадагаскара, которые вырастают до 10 см.
- Как декоративное животное, не нуждающееся в сложном уходе.
Как корм для некоторых обитателей террариума.
- Как ингредиент традиционных блюд китайской кухни, например, засахаренные тараканы. В этих насекомых содержится в 3 раза больше белка, чем в курице.
- По некоторым сведениям, тараканы используются и в традиционной народной медицине.
- Тараканы нередко становились героями повестей, песен, мультфильмов и других произведений искусства.
Тараканы — представители отряда, который насчитывает более 7,5 тысяч видов, из которых более половины — непосредственно тараканы. Они различаются местом обитания, внешним видом и поведением, однако все представители имеют много общего. Для человека эти насекомые могут быть крайне опасны, так как распространяют микробов и опасные болезни.
Социальная структура и размножение
Женщинам-тараканам не нужен самец, чтобы откладывать яйца, но им нравится компания. Новое исследование показывает, что девственные самки тараканов, живущие в обществе, производят потомство быстрее, чем девственные самки, живущие в одиночестве.
Не особенно приятно представлять, что это происходит под холодильником, но самки американских тараканов могут производить яйца путем партеногенеза, типа бесполого размножения. Как и многие другие членистоногие, которые могут размножаться таким образом, тараканы, как правило, делают это, только если самцы недоступны. Потомки, рожденные в результате партеногенеза, развиваются только из материнской яйцеклетки, поэтому у них меньше генетическое разнообразие, чем у потомства, созданного половым размножением.
У американских тараканов яйца, полученные в результате партеногенеза, имеют более низкую выживаемость, чем яйца, полученные после полового акта, но потомство одиноких мам способно выживать и спариваться.
Исследователи выяснили, что нехватка самцов не могла быть единственной причиной партеногенеза. Самки должны иметь возможность различать не только общее отсутствие мужчин, но и долю мужчин, связанных с ними, и вероятность найти партнера по конкретной плотности населения.
Чтобы проверить влияние социальной среды, исследователи помещали самок тараканов в разные ситуации. В контрольной группе самец и самка содержались вместе, им разрешалось спариваться. В других случаях женщины содержались с одной, двумя, тремя или четырьмя другими самками. Третья группа самок содержались с кастрированными самцами. Исследователи также проверили эффекты добавления феромонов, химических веществ, которые насекомые используют для общения, в группы тараканов, состоящих исключительно из женщин.
Затем исследователи подсчитали количество яиц, откладываемых в каждом состоянии, и сколько времени потребовалось самкам, чтобы отложить яйца. Они обнаружили, что девственные тараканы в одиночку откладывают яйца посредством партеногенеза в среднем через 13 дней, плюс или минус около четырех дней. Девственные тараканы, содержавшиеся в группах, значительно чаще повторно откладывали яйца. Например, самки тараканов, содержавшиеся строем, начали откладывать яйца в среднем через 10 дней, плюс или минус пару дней.
У тараканов есть чувство солидарности. Девственные тараканы, содержащиеся в группах, состоящих только из самок, откладывают свою вторую кладку яиц гораздо раньше, чем девственные тараканы, оставленные в одиночестве (в среднем 18 дней против 25—30 дней для изолированных тараканов).
Добавление феромонов не сократило время тараканов к партеногенезу, хотя пребывание с кастрированными самцами задерживало процесс больше, чем с самками, обнаружили исследователи.
Синхронизируя партеногенез, самки в группе могут извлечь выгоду, обеспечив выживание большего числа своих потомков, писали исследователи. Вылупившиеся вместе тараканьи нимфы будут в безопасности, что может противостоять недостатку, заключающемуся в том, что они вылупляются с более низкими показателями, чем потомство, полученное в результате полового размножения.
Исследователи добавили, что это может быть очень примитивным примером женского сотрудничества. В то время как размещенные вместе тараканы-самцы, как правило, сражаются до тех пор, пока не откусят усики друг друга. Самки наоборот сбиваются в кучу и, по-видимому, даже согласовывают свои репродуктивные графики. Это связано с общей экологией популяции, так как самцы, как правило, покидают колонии, чтобы избежать инбридинга, в то время как самки сородичей держатся вместе.
Образ жизни
Для представителей вида характерен ночной образ жизни. В светлое время они скрываются под корой деревьев, в лиственной подстилке, под корнями. С наступлением темноты выбираются за кормом. Основное время проводят в нижнем ярусе, но иногда по шероховатой коре забираются на деревья и бегают по веткам. Насекомые всеядны, питаются фруктами и другой растительностью, поедают органические остатки. В случае опасности имаго выделяют неприятный запах из желез на брюшке.
Размножение
Самец интересно ухаживает за самкой, поднимая длинные крылья. Он совершает своеобразный ритуальный танец для привлечения партнерши. Для спаривания самка залезает на спину самца. Процесс занимает 30-60 минут. Архимандриты относятся к яйцеживородящим видам. Самка вынашивает оплодотворенные яйца внутри брюшка. Как и у других тараканов они находятся в белковой капсуле оотеке, но не покидают тела надолго. Инкубационный период занимает 90-120 дней.
Во время продолжительного вынашивания потомства самка несколько раз высовывает оотеку наружу для проветривания. Капсула розового цвета. В момент появления потомства самка сбрасывает капсулу. Количество рожденных личинок 20-30 штук. Они вместе матерью поедают оотеку из которой появились. Длина личинок не превышает 7 мм.
Нимфы похожи на бескрылые взрослые особи. У них на желтой переднеспенке имеется черное пятно. Окраска тела коричневая, вдоль брюшка проходит 6 рядов желтых пятен. Ноги черные, щетинистые. Хитиновый покров тела шершавый, частицы земли, попавшие в неровности, делают личинку неприметной. Развитие личинки занимает 8-12 месяцев. Период достижения половой зрелости зависит от многих факторов: температуры, влажности, количества корма.
От имаго потомство отделяет не менее 8 линек. Промежуток между ними составляет 20-40 дней. Маленький таракан сбрасывает темный покров и через сутки обрастет новым. В этот период он особенно уязвим к нападению, поэтому прячется в укрытии. При внимательном наблюдении можно заранее определить подготовку питомца к сбрасыванию панциря. В первую очередь меняется хитин на фасеточных глазах, их цвет меняется от черного к серому. Хитиновый покров лопается вдоль тела, начиная с головы. Нимфа выбирается из старого панциря, который вскоре съедает.
В последнем возрасте личинок называют предимаго. Им остается последняя линька, после которой таракан приобретает крылья и вид взрослой особи. За 2 дня до события нимфа становится вялой и малоподвижной. Для линьки она забирается на возвышение, чтобы после сбрасывания панциря иметь возможность расправить крылья.
Необычные виды тараканов
Кроме насекомых, паразитирующих в человеческом жилище, существует достаточно большое количество экзотических видов. Террариумисты с удовольствием разводят огромных тараканов и даже дружат с ними.
Шахматный таракан (Therea petiveriana)
Обитает в южной Индии, ведет ночной образ жизни. В дневное время прячется в опавшей листве, под деревьями, зарывается под корни растений. В длину достигает 2,5 сантиметра. Название дано благодаря необычной окраске – белым пятнам на черном фоне.
Шахматный таракан никоим образом не напоминает домашних насекомых. Содержат их в пластмассовой коробке на защелках. Требуется специальный грунт, состоящий из рыхлой земли, торфа, кокосового субстрата.
Кормят шахматных тараканов морковью, грушами, хлебом. Не допускается наличие в коробке гниющих остатков.
Мадагаскарский шипящий таракан (Gromphadorhia portentosa)
Достигает в длину девять сантиметров. В природе живет 1 – 2 года, в искусственных условиях и при хорошем уходе возраст может достигать пяти лет. При испуге или необходимости защиты мадагаскарский таракан начинает шипеть.
Для разведения требуется небольшой террариум с крышкой, которая не должна плотно прилегать. В то же время щель должна быть достаточно узкой, чтобы насекомое не смогло выползти – на лапках таракана имеются специальные присоски, которые дают возможность насекомому возможность передвигаться по абсолютно гладкой поверхности.
В качестве корма дают травянистые части растений и фрукты.
Таракан «мертвая голова» (Blaberus cranifer)
Достигает в длину 5,5 сантиметра. Название получил из-за характерного пятна на спинке, напоминающего череп. Днем прячется в листьях, вечером и ночью выходит на охоту. Питается мелкими насекомыми.
При содержании в террариуме требуется добавлять в пищу собачий корм. Если этого не сделать, тараканы начинают поедать друг друга.
Требует осторожного обращения. При испуге может укусить или уколоть шипами. Чтобы представить, как выглядят экзотические виды, лучше всего посмотреть, как выглядят тараканы на фото
Современные технологии позволяют получить снимки высокого качества, при этом можно разглядеть малейшие детали в строении насекомых
Чтобы представить, как выглядят экзотические виды, лучше всего посмотреть, как выглядят тараканы на фото. Современные технологии позволяют получить снимки высокого качества, при этом можно разглядеть малейшие детали в строении насекомых.
Лимитирующие факторы и защита
Сокращению численности вида способствует вырубка старых лесных насаждений и засадка песчаных участков. Локально обитающие группы часто гибнут от лесных пожаров, в результате разрушения почвы.
Скакун лесной является исчезающим видом, он занесен в Красные книги нескольких областей России: Воронежской, Калужской, Московской, Владимирской. Рекомендуется выявлять места обитания жуков и брать их под охрану, создавая ООПТ. На участках проживания вида запрещается вырубка сосняков, ограничивается обработка химическими препаратами соседних биоценозов
Важно не допустить зарастания песчаных стаций кустарником и травами
Приносимый вред
Порча продуктов – полбеды по сравнению с другими возможными проблемами. Таракан – один из путей распространения заболеваний. В основном распространяемые болезни относятся к группе инфекций ЖКТ:
- дизентерия;
- гастроэнтерит;
- инфекционная диарея;
- сальмонеллез.
Болезни
Болезни
И прочие подобные инфекции. Насекомые разносят их механическим путем.
Прусаки контактируют с отбросами в мусорных ведрах, канализационными трубами и грязью, скопившейся в щелях. После этого насекомые отправляются питаться свежими продуктами, оставляя бактерии на поверхности человеческой пищи.
При большом количестве вредителей в помещении их разрушающиеся хитиновые панцири могут вызывать аллергию.
Внешний вид и среда обитания
Тараканы – одни из древнейших обитателей планеты. Семейству Blattoptera помогали выживать исключительные способности: возможность долго жить без воды, всеядность, неприхотливость и маневренность. За 300 млн лет существования они мало изменились внешне. У мексиканских тараканов приплюснутое овальное тело, длина которого составляет 6,5-8,5 см. Самки светло-соломенного цвета, некоторые особи достигают 9-10 см. Самцы кремовые, у них более стройное тело, максимальная длина 7,5 см. Брюшко состоит из 7-9 склеротизированных сегментов.
У тараканов нет легких, их заменяют дыхальца – эти органы расположены по бокам тела. В их системе кровообращения содержится гемолимфа. Надкрылья плотные, кожистые, посередине проходит поперечная темная полоса. Она коричневого или черного цвета. Длинные крылья выходят за генитальную пластинку. В сложенном состоянии они прячутся под надкрыльями. На переднеспинке есть черное пятно трапециевидной формы. Сам щиток широкий и плоский, прозрачный по краям. Усики длинные, серого цвета. Они служат антеннами, улавливающими сигнал от других тараканов. У насекомого три пары ног, состоящих из 5 члеников. Голени и бедра покрыты шипами.
Обитатель влажных лесов Центральной и Южной Америки называется Блаберус гигантеус (Blaberus giganteus) или гигантский лесной или пещерный таракан. Он быстро бегает по земле, легко меняя направление. Спрыгивая с деревьев или камней, насекомые пролетают значительные расстояния. Они живут группами, которые можно встретить в сырых пещерах, трещинах горных пород, лесной подстилке. Большую часть дня проводят в состоянии покоя. Активность начинается в сумерках. Насекомые отправляются искать пищу и воду. Рацион тараканов состоит из растительных остатков, фруктов, мертвых животных, помета летучих мышей.
Взрослые мексиканские тараканы и нимфы значительно отличаются внешним видом. Личинки широкие, коричневого цвета, не имеют крыльев. На брюшке узор из желтых пятен. Посередине четыре вертикальных ряда треугольных пятен, по краям они округлые и слабозаметные. На первый взгляд блаберус гигантеус и его нимфы совершенно не похожи на родственников.
Половые различия насекомых наблюдается в размерах – самец мельче самки и в строении придатков. У мужских особей в задней части брюшка есть орган похожий на иголки, у самок он отсутствует. Проще всего различить особи по характерному поведению. Самцы активно ухаживают за партнершами.
Дыхательная система Насекомых
Дышат с помощью трахей. Они ветвятся и оплетают все органы, входят даже в отдельные клетки в виде трахеол. Наружу открываются 10 пар дыхалец или стигм – отверстий по сторонам брюшка и груди. В передней части брюшка, груди трахеи расширяются и образуют воздушные мешки. Через трахеи осуществляется газообмен (поглощается кислород, выводится углекислый газ), удаляются водные пары. Осуществляется дыхание вследствие ритмического сокращения и растяжения боковых и продольных мышц брюшка. Личинки некоторых насекомых дышат с помощью трахейных жабр (стрекоз, однодневок). Это образования на поверхности тела или в задней кишке, которые имеют вид лепестков с разветвленными трахеями в середине. Трахейная система – замкнутая (дыхалец нет). Кислород поступает в трахеи из жабр.
Правила содержания
Ответ на вопрос, чем кормить мадагаскарских тараканов, будет очень прост. Насекомые отдают предпочтение: овощам, фруктам и зелени.
Продукты для кормления могут быть свежими, однако так же идут в употребление и перегнивший корм. Некоторые представители, могут с легкостью съесть даже своего мертвого соседа. Для упругости панциря, необходимым условием будет вводить в питание своего питомца продукты богатые на кальций. Наиболее важным это условия является для молодых особей и на время периода размножения.
Хорошим местом для домашних мадагаскарских тараканов будет террариум, имеющий размеры 0,2х0,3х0,4 м., в нем с легкостью может поместиться порядка 30 особей. Благодаря наличию мягких подушек на лапках, насекомые имеют возможность передвигаться по ровной плоскости. Следовательно, во избежание побега своих домашних питомцев, необходимым условием является наличие плотно прилегающей крышки. Что касается доступа воздуха, то он попадает в террариум через маленькие дырочки.

Если же произойдет такая неприятность, как побег одного из питомцев, хозяину не стоит впадать в панику и бить тревогу, поскольку угрозу для жизни эти насекомые не представляют. Даже если в семье есть маленькие дети, содержание шипящих тараканов также возможно, только следить за тем, чтобы таракан не убежал из клетки стоит более тщательно. Единственным условием, при котором нельзя заводить таких домашних животных – это наличие аллергической реакции у кого-то из жильцов дома.
Интересные факты
В связи с тем, что черные тараканы известны человечеству более 3-х столетий, в разные времена появлялись различные поверья и необычные факты, связанные с этими насекомыми. Например, в старину тараканы часто прятались за теплой печкой, отчего их стали называть «запечными жителями».
Также существовало придание, что появление в доме черных усачей сулило хозяевам богатство, поэтому их даже подкармливали и брали с собой при переездах в новое жилье. Древние знахари готовили из тараканов лечебное зелье, применяемое при расстройствах пищеварения. Оно состояло из чеснока и обжаренных в масле насекомых.
Также в медицине применялся чай из сушеных тараканов в качестве мочегонного средства. Современная же медицина в отношении тараканов сообщает о высоком проценте аллергических реакций на насекомых среди маленьких детей, проживающих в крупных городах (примерно 45 %).
В азиатских странах, таких как Таиланд, Южная Корея, Камбоджа и Вьетнам тараканы по сей день считаются обязательным компонентом многих блюд национальной кухни. Их едят жареными, тушеными и высушенными, а также предлагают попробовать всем туристам. Подобные пищевые пристрастия объясняются высоким содержанием качественного белка в теле насекомых.
Ученые энтомологи в процессе многолетнего изучения разных насекомых обнаружили интересный факт, что на тараканов не оказывает воздействие радиация, ввиду их замедленных биологических процессов.
По данным археологических раскопок тараканы появились еще в период обитания динозавров и достигали размеров 50 см в длину и более. Современные данные подтверждают еще один факт – тараканы способны чувствовать приближение сильного дождя, отчего старательно спешат укрыться даже ночью.
Жизнь тараканов неразрывно связана с бытом человека, отчего нередки случаи появлении сновидений с участием этих насекомых. Чтобы понять к чему снятся черные тараканы следует обратиться к специализированным книгам-толкователям.
В большинстве своем подобные сновидения сообщают о радостных событиях, успехе в делах и благополучии (даже если насекомых было очень много, и они нападали на человека).
Сон с участием тараканов гигантских размеров может стать предупреждением о возможных интригах со стороны влиятельных родственников или знакомых. А вот если во сне появился белый таракан – стоит ожидать неприятностей.
Виды летающих тараканов
За 300 миллионов лет существования у представителей отряда таракановых значительно уменьшился яйцеклад и частично изменились крылья. У большинства современных видов одна пара крыльев превратилась в прочные надкрылья, а вторая частично редуцировалась. В основном летательные функции сохранились у представителей тропической фауны.
Зеленый банановый таракан
В тропических лесах Карибских островов, Кубы и Флориды водятся представители вида Panchlora nivea. Они небольшого размера 17-22 мм. Светло-зеленые имаго прекрасно прыгают и летают, личинки предпочитают зарываться в грунт. В вечернее время взрослые особи активно летят на свет, днем подлетают к цветущим банановым пальмам за нектаром. Личинки питаются растительными остатками.
Megaloblatta longipennis
Обитатели Южной Америки (Эквадор, Перу) являются самыми крупными тараканами с крыльями. Длина их тела составляет 76-95 мм, размах крыльев до 200 мм. Насекомые занесены в Книгу рекордов Гиннеса. Вторая характерная особенность вида – высокая плодовитость самки. За свою жизнь она откладывает около 50 коконов с яйцами, давая начало целой колонии.
Гигантский пещерный (лесной) таракан или Blaberus giganteus
Насекомые встречаются в лесах Центральной и Южной Америки. Имаго живут на деревьях, а личинки закапываются в подстилку. Самки крупнее самцов, длина тела соответственно 8 см и 7 см. Крылья хорошо развиты насекомые перелетают с ветки на ветку, планируют с высоты. Любители экзотики часто заводят Блаберусов.
Летающие тараканы используют крылья во время брачных ухаживаний за самкой. Для привлечения партнерши используются не только феромоны, но специальные движения. Самец поднимает широкие прозрачные крылья, помахивает ими, издавая при этом стрекочущий звук. Если партнерша принимает ухаживания, крылья поднимаются полностью и она взбирается на спину самца.
Черепашка Соссюра
Насекомые родом из Средней Азии, обитают в глинистых пустынях. У вида развит половой диморфизм. Самки округлые, выпуклые, напоминают черепашек. Длина тела 45-50 мм. Их крылья атрофировались. Самцы овальные, темные, имеют длинные развитые надкрылья. Сохранили способность к полету.
Лапландский таракан
Европейский вид, интродуцированный в США. Насекомые небольшого размера, самцы 13-14 мм, самки – 9-10 мм. Мужские особи предпочитают проводить время на низких деревьях и кустарниках, порхать между ветками. Самки держатся в подстилке.
Азиатский таракан
Внешне насекомые являются близнецами прусаков, в некоторых случаях отмечалось межвидовое скрещивание. Они обитают в субтропических областях Азии. Вид был завезен в США, где распространился в южных штатах. Имаго имеют длинные крылья, активно летят на свет. Местами обитания являются травянистые заросли и лиственная подстилка.
Питание
- Все стрекозы являются стопроцентными хищниками. Одни из них предпочитают ловить жертву в полете, другие — хватать сидящую на земле или растениях добычу.
- Стрекозы являются фантастически эффективными охотниками. 95% их атак заканчиваются успехом. Для сравнения, акулы ловят примерно половину, а львы – четверть намеченных ими жертв.
- Стрекоза прожорлива и не привередлива в еде. Вес её дневного рациона может в разы превысить вес самой хищницы. Любимая добыча – мухи и комары, но стрекоза готова атаковать любое насекомое, с которым может справиться.
- Челюсти стрекозы могут раздвигаться практически на всю ширину головы, позволяя без помех съесть даже крупную добычу. Поэтому хищница часто употребляет пищу прямо в воздухе, даже не потрудившись приземлиться.
Уже понятны страшные способы питания личинок таких существ. К тому моменту, когда они вылупляются из яиц и начинают развиваться, родители их уже позаботились о том, чтобы еды у них было достаточно. Ведь заражённые ими организмы существенно страдают далеко не сразу. Они не просто живут, но растут, развиваются и питаются, поначалу мало замечая, что внутри их зреет паразит. Но со временем им уготована страшная судьба.
Так или иначе паразитируют абсолютно все разновидности наездников. Но интересно, что взрослые особи в некоторых случаях вообще ничего не едят. Однако, другие всё-таки нуждаются в корме. В этом случае наездник питается либо выделениями других насекомых, либо нектаром или пыльцой растений.
Органы чувств Насекомых
На голове – 1 пара усиков (органы обоняния и осязания). Разнообразное строение усиков: гребенчатые, булавовидные, нитевидные, пластинчатые, щетинковидные, пильчатые и т. п. Орган зрения – сложные (фасеточные) глаза, иногда есть простые (1 – 3). Каждый сложный глаз состоит из большого количества фасеток (нескольких тысяч). Большинство насекомых не воспринимает красного цвета, но хорошо воспринимает ультрафиолетовое излучение. Простые глазки (не способные воспринимать изображение) реагируют на степень освещенности, могут воспринимать поляризованный свет. Личинки насекомых с полным превращением имеют боковые глазки (от одной до нескольких пар). Каждый такой глазок может воспринимать изображения предметов. Тело, конечности покрыты волосками, чешуйками, которые являются рецепторами вкуса, осязания и т. п. Некоторые насекомые имеют орган слуха (у кузнечиков – на передней паре ног и т. д.).
Образ жизни
Самый крупный таракан в мире живет до 1-1,5 лет, в неволе – до трех. Редко взрослые особи могут дожить до 5 лет.
Их рацион питания – это гниющие остатки плодов, ягод и зеленых частичек растений. Чаще всего эти насекомые обитают под колодами в лесу, на ветках деревьев и в трухлявых пнях.
Размножение
Эти тараканы – насекомые живородящие. После того как самка оплодотворится, она не откладывает яйца, а вынашивает потомство в животе. Через 50 – 70 дней появляются 20-40 штук маленьких тараканчиков белого цвета с черными глазами. Размер их всего несколько миллиметров. Через несколько часов наружный покров огрубевает, и личинки становятся коричневого цвета.
Самые большие тараканы заботливо относятся к личинкам, которые только появились на свет. Пару дней они находятся возле матери, потом расползаются. Пока личинки не разлезутся в разные стороны, самка, оберегая их, гневно шипит на других насекомых и животных.
Хитиновый покров личинки не растет, поэтому таракан растет в нем. Периодически у нимфы происходит линька: трескается старый панцирь, и из него выходит светлая, подросшая личинка. Она имеет мягкий новый панцирь и начинает поедать свою бывшую оболочку.
Пока нимфа это делает, ее покровы затвердевают и приобретают коричневый цвет. Линяют молодые насекомые 6 раз, последний – в 5- 6 месяцев после рождения.
Сегодня мы поговорим о том, что из себя представляет черный таракан. Эта разновидность вредителя менее устойчива к воздействию инсектицидных средств, а также агрессивному воздействию окружающей среды, поскольку именно этот вид, в отличие от обычных рыжих тараканов, сравнительно недавно адаптировался к жизни рядом с человеком. По этой причине черного тарана можно встретить в жилых помещениях гораздо реже чем, его рыжих собратьев тем не менее, он все же попадается время от времени.
Чем питаются черные тараканы?
Вместо того, чтобы спрашивать «что едят тараканы», было бы легче ответить на вопрос о том, что они не едят. Почему? Потому что эти падальщики являются одними из самых требовательных едоков в царстве насекомых.
У тараканов есть три элемента, работающих вместе. Это то, чем они отличаются от других домашних вредителей. Во-первых, тараканы всеядны. Это означает, что они едят как растения, так и животных, им все равно. Во-вторых, тараканы — оппортунистические едоки. Они будут есть все, что есть у вас дома, если только это соответствует третьему пункту: пища должна быть органической (то есть не металлической, пластиковой и т. д.).
Тараканы — древние и весьма успешные насекомые. Они практикуют много привычек, чтобы выжить, в том числе:
- они едят свои собственные фекалии!
- они едят свою собственную рвоту!
- они едят свой собственный вид
Тараканы будут поглощать большинство тех продуктов, которые вам нравятся. В конце концов, люди тоже всеядны, поэтому неудивительно, что у нас одинаковые вкусы. Вот почему вы найдете тараканов на кухнях, в местах хранения продуктов и в местах приготовления пищи в домах с заражениями.
Теперь, если бы ваша кухня была рестораном, тараканы определенно заказывали бы одни виды продуктов раньше других. Сладости, крахмалы и животные белки — любимая еда тараканов. Они также любят жирную пищу, сыр или все, что заплесневело или заквашено
Соблюдайте особую осторожность, храните сладкие продукты в герметичных контейнерах, очищайте разделочные доски после приготовления мяса и вытирайте стол после того, как нарезали хлеб и от других оставшихся крошек
Чистота является важной частью профилактики тараканов
Если в вашем «ресторане» нет «любимых» тараканьих блюд, они, увы, не отправятся в другое место. Они будут изучать, чтобы выяснить, что еще есть в меню, снимая пробу со всего на своем пути. Разлагающиеся вещества способствуют развитию их аппетита, поэтому мусор и отходы — даже человеческие отходы — будут служить изысканной едой для черного таракана. Сгодятся для еды растения, мыло и косметика.

























































